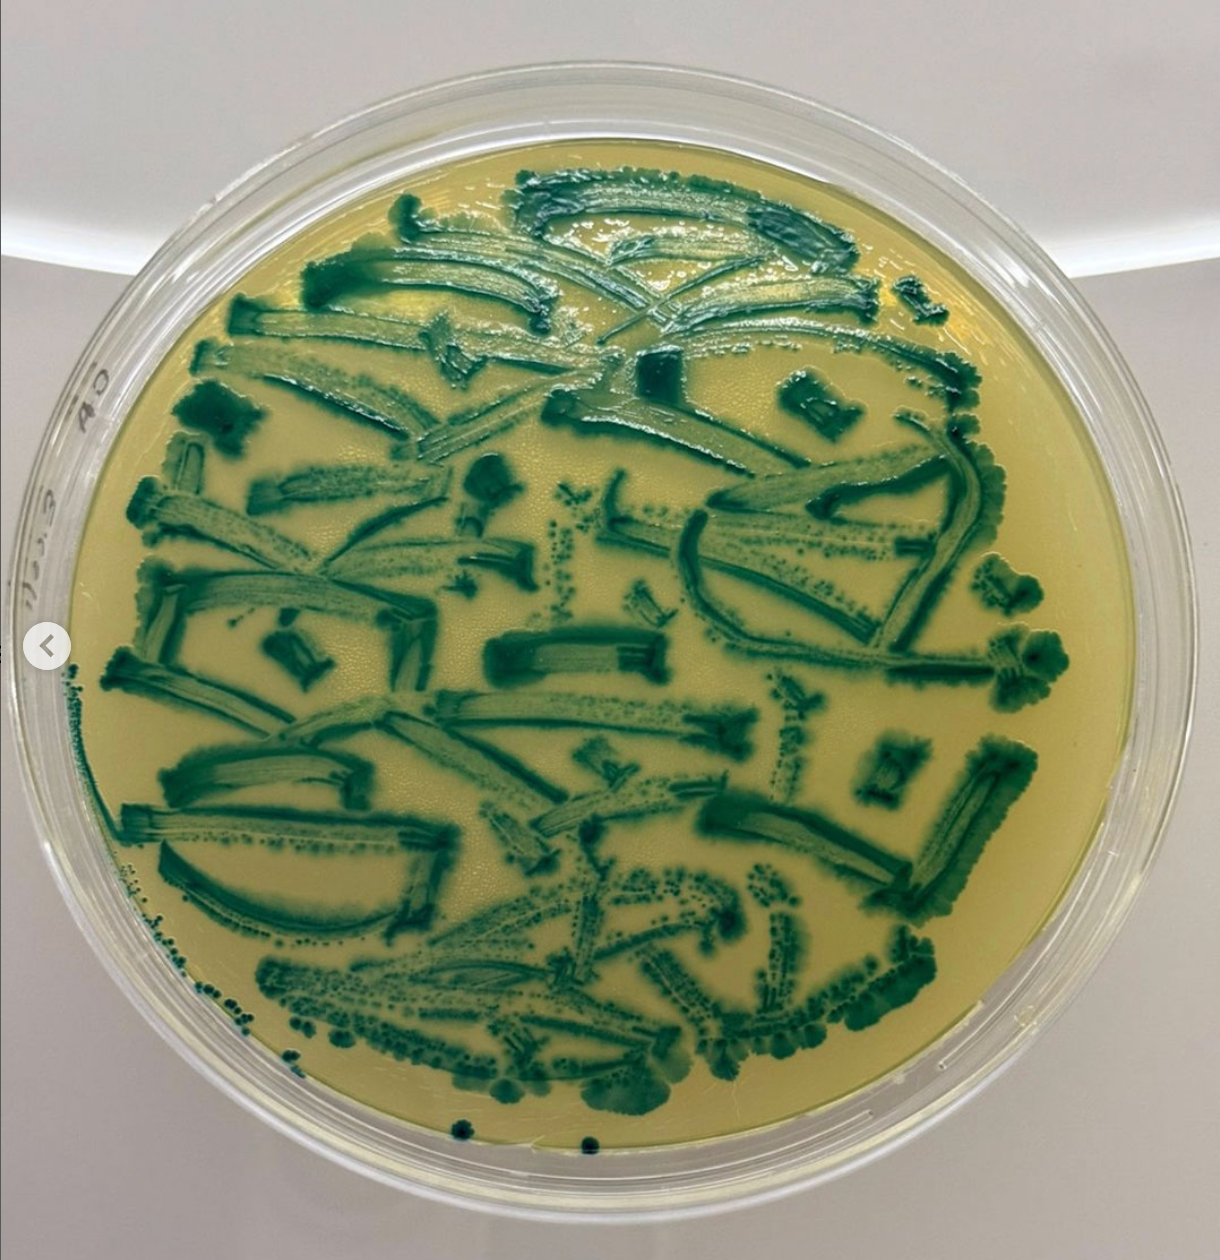
Screenshot 2025-12-01 at 10.31.30 a.m.

Inscripciones: Trabajando el Backend de una Obra de Nivel Internacional
Trabajar con artistas de renombre en obras de alto nivel, expuestas en museos importantes del país, no es un camino fácil. Este camino está lleno de horas extra y, a menudo, ofrece un bajo nivel de reconocimiento.
Samuel I. Ramirez-Navarro
1-12-2025